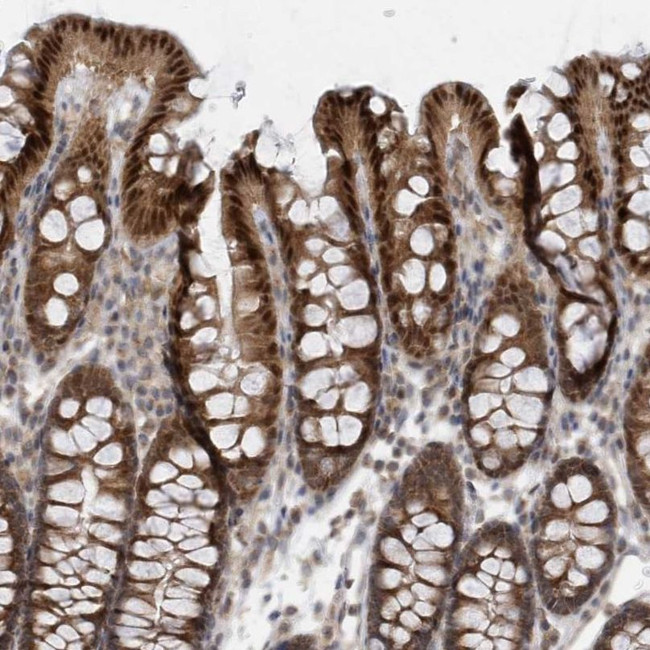
MXI1 Antibody in Immunohistochemistry (IHC)

Search
Invitrogen
MXI1 Polyclonal Antibody
{{$productOrderCtrl.translations['antibody.pdp.commerceCard.promotion.promotions']}}
{{$productOrderCtrl.translations['antibody.pdp.commerceCard.promotion.viewpromo']}}
{{$productOrderCtrl.translations['antibody.pdp.commerceCard.promotion.promocode']}}: {{promo.promoCode}} {{promo.promoTitle}} {{promo.promoDescription}}. {{$productOrderCtrl.translations['antibody.pdp.commerceCard.promotion.learnmore']}}




Please note: We are reviewing Western blot images included in the antibody testing data in our catalog, including those provided by third parties. Unless expressly labeled or annotated as “raw-unedited”, Western blot images included in the antibody testing data in our catalog may have been edited, optimized or otherwise adjusted for presentation.
产品信息
PA5-57225
种属反应
宿主/亚型
分类
类型
抗原
偶联物
形式
浓度
规格
纯化类型
保存液
内含物
保存条件
运输条件
RRID
产品详细信息
Immunogen sequence: HTTLGLLNKA KAHIKKLEEA ERKSQHQLEN LEREQRFLKW RLEQLQGPQE MERIRM
Highest antigen sequence identity to the following orthologs: Mouse - 98%, Rat - 98%.
靶标信息
It is now well established that Myc regulation of cell proliferation and differentiation involves a family of related transcription factors. One such factor, Max, is an obligate heterodimeric partner for Myc and can also form heterodimers with at least four related proteins designated Mad 1, Mxi1, Mad 3 and Mad 4. Like Mad 1 and Mxi1, association of Mad 3 and Mad 4 with Max results in transcriptional repression. Both Myc and the Mad proteins have short half-lives and their synthesis is tightly regulated, while Max expression is constitutive and relatively stable. Two related mammalian cDNAs have been identified and shown to encode Mad-binding proteins. Both possess sequence homology with the yeast transcription repressor Sin3 including four conserved paired amphipathic helix (PAH) domains. mSin3A and mSin3B specifically interact with the Mad proteins via their second paired amphipathic helix domain (PAH2). It has been suggested that Mad-Max heterodimers repress transcription by tethering mSin3 to DNA as corepressors.
仅用于科研。不用于诊断过程。未经明确授权不得转售。
篇参考文献 (0)
生物信息学
蛋白别名: bHLHc11; Class C basic helix-loop-helix protein 11; Max interactor 1; Max-interacting protein 1; MGC43220; RP11-549L6.1
基因别名: BHLHC11; MXI1
Entrez Gene ID: (Human) 4601